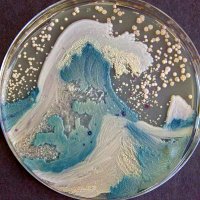
Guig 🔻 (@bobopopo67) 's Twitter Profile Photo

Michaël 🐊
@mimiryudo
Médecin généraliste masqué MD-PhD • Certificats-absurdes.fr • BioMG.fr • Co-fondateur Stop-Postillons & @Cote_Science • Scénariste @Netophonix @Etlaterreeclata
ID: 57711739
http://www.mimiryudo.com 17-07-2009 18:08:23
107,107K Tweet
17,17K Takipçi
8,8K Takip Edilen




Donnons un petit souffle à cette tribune dans L'Express sur la qualité de l'air dans les écoles, pour qu'elle arrive jusqu'au congrès des maires de AMF | Association des maires de France présidé par David Lisnard. N'hésitez pas à faire un mail (ou commentaire sur Facebook) à votre maire pour échanger ;)

Emmanuel Macron François Bayrou Marc Ferracci Agnès Pannier-Runacher 🇫🇷🇪🇺 ADEME CRE EDF RTE Enedis ENGIE TotalEnergies Euroheat & Power EHP European Commission CEA Paris-Saclay CNRS 🌍 INES CEA-Liten CEA Cerema Belle initiative en lien avec #respire_encore, espérons que les élus comprennent. Sénat Assemblée nationale Haute Autorité de santé Assurance Maladie Humain ou machine, le préventif coûte toujours moins cher que le correctif!


Voilà une tribune qui ne manque pas d’air ! #Covid19 ersin leibowitch Marie Bernardeau Anne Le Gall Solenne LE HEN anne laure dagnet Nicolas Berrod

France Michaël 🐊 (n° vert : 0 800 900 1000) AMF | Association des maires de France Merci ! Si nos politiques avaient un peu de hauteur de vue ils se rendraient compte qu'en plus c'est un investissement rentable !


A votre disposition pour en parler Jean-René Etchegaray Maider AROSTEGUY CLAUDE OLIVE ou quiconque au sein de la CommunautéPaysBasque







